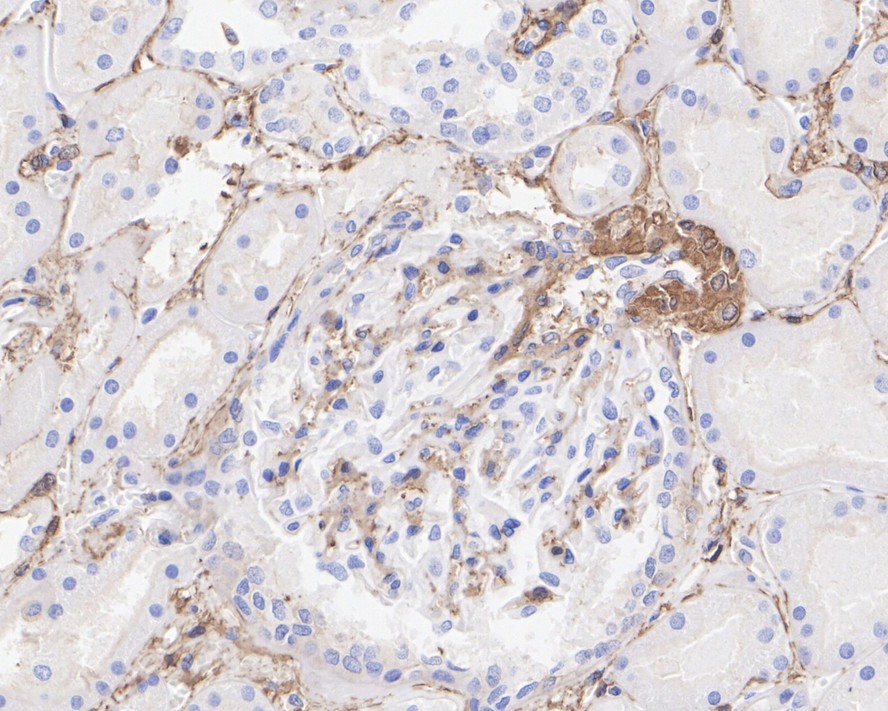
HA750126_9.jpg

alpha smooth muscle Actin Recombinant Rabbit Monoclonal Antibody [SY02-64]

cat.: HA750126
| Product Type: | Recombinant Rabbit monoclonal IgG, primary antibodies |
|---|---|
| Species reactivity: | Human, Mouse, Rat |
| Applications: | WB, IF-Cell, IF-Tissue, IHC-P, FC |
| Clonality: | Monoclonal |
| Clone number: | SY02-64 |
| Form: | Liquid |
| Storage condition: | Store at +4℃ after thawing. Aliquot store at -20℃ or -80℃. Avoid repeated freeze / thaw cycles. |
| Storage buffer: | 1*PBS (pH7.4). |
| Concentration: | 0.05ug/ul |
| Purification: | Protein A affinity purified. |
| Molecular weight: | Predicted band size: 42 kDa |
| Isotype: | IgG |
| Immunogen: | Synthetic peptide within N-terminal human alpha smooth muscle Actin. |
| Positive control: | Saos-2 (Human osteosarcoma cells) cell lysate, A431 (Human epidermoid carcinoma skin squamous cells) cell lysate, NIH/3T3 (Mouse fibroblasts) cell lysate, C2C12 (Mouse myoblasts) cell lysate, Neuro-2a (Mouse brain neuroblastoma cells) cell lysate, Mouse skin tissue lysate, Rat skin tissue lysate. |
| Subcellular location: | Cytoplasm. |
| Recommended Dilutions:
WB IF-Cell IF-Tissue IHC-P FC |
1:1,000-1:5,000 1:2,000-1:5,000 1:50-1:200 1:1,000-1:5,000 1:1,000-1:2,000 |
| Uniprot #: | SwissProt: P62736 Human | P62737 Mouse | P62738 Rat |
| Alternative names: | alpha SMA a-SMA asma a actin AAT6 ACTA_HUMAN ACTA2 Actin alpha 2 smooth muscle aorta Actin aortic smooth muscle Actin, aortic smooth muscle ACTSA ACTVS Alpha 2 actin Alpha actin 2 Alpha cardiac actin Alpha-actin-2 Cell growth inhibiting gene 46 protein Cell growth-inhibiting gene 46 protein GIG46 Growth inhibiting gene 46 MYMY5 |
Images

|
Fig1:
Application: IF-tissue Species: Human Site: Kidney Sample: Paraffin-embedded section Antibody concentration: 1/50 |

|
Fig2:
Application: IF-tissue Species: Human Site: Stomach cancer Sample: Paraffin-embedded section Antibody concentration: 1/50 (alpha smooth muscle Actin, HA750126, red) and 1/100 (ALDH2, M1509-1, green) |

|
Fig3:
Application: IF-tissue Species: Mouse Site: Liver Sample: Paraffin-embedded section Antibody concentration: 1/50 |

|
Fig4:
Western blot analysis of alpha smooth muscle Actin on different lysates with Rabbit anti-alpha smooth muscle Actin antibody (HA750126) at 1/2,000 dilution. Lane 1: Saos-2 (Human osteosarcoma cells) cell lysate Lane 2: A431 (Human epidermoid carcinoma skin squamous cells) cell lysate Lane 3: NIH/3T3 (Mouse fibroblasts) cell lysate Lane 4: C2C12 (Mouse myoblasts) cell lysate Lane 5: Neuro-2a (Mouse brain neuroblastoma cells) cell lysate Lane 6: Mouse skin tissue lysate Lane 7: Rat skin tissue lysate Lysates/proteins at 15 µg/Lane. Exposure time: 2 seconds; ECL: K1801 Blocking: 5% NFDM/TBST, 1 hour at room temperature Primary antibody: HA750126, 1/2,000 in primary antibody dilution buffer (K1803), overnight at 4 ℃ Secondary antibody: Goat anti-Rabbit IgG-HRP (HA1001), 1/50,000 in 5% NFDM/TBST, 1 hour at room temperature Predicted band size: 42 kDa Observed band size: 42 kDa |

|
Fig5:
Application: Immunocytochemistry (IF-cell) Species: Human Sample: Hep G2 (Human liver cancer cells) Fixation: 4% Paraformaldehyde, 15 minutes at room temperature. Permeabilization: 0.1% Triton X-100, 15 minutes at room temperature. Blocking: 1% BSA + 10% normal goat serum, 1 hour at room temperature. Antibody dilution buffer: 1% BSA in PBST. Primary antibody: HA750126, 1/2,000, overnight at 4℃. Secondary antibody: Goat Anti-Rabbit IgG (iFluor™ 488, HA1121), 45 minutes at room temperature. Counterstain: Beta tubulin (HA601187, red), 1/100, overnight at 4℃. The Nuclear counterstain was DAPI (Blue). |

|
Fig6:
Application: Immunohistochemistry (IHC-P) Species: Human Tissue: Breast carcinoma Sample: Paraffin-embedded section Antigen retrieval: Heat-mediated, Tris-EDTA buffer (pH 9.0), 20 minutes at 95℃. Wash buffer: 1× TBST Endogenous peroxidase blocking: 3% H₂O₂, 10 minutes at room temperature. Blocking: 1% BSA + 10% normal goat serum, 10 minutes at room temperature. Primary antibody: HA750126, 1/1,000, 1 hour at room temperature. Secondary antibody: HA1119, 20 minutes at room temperature. |

|
Fig7:
Application: Immunohistochemistry (IHC-P) Species: Mouse Tissue: Small intestine Sample: Paraffin-embedded section Antigen retrieval: Heat-mediated, Tris-EDTA buffer (pH 9.0), 20 minutes at 95℃. Wash buffer: 1× TBST Endogenous peroxidase blocking: 3% H₂O₂, 10 minutes at room temperature. Blocking: 1% BSA + 10% normal goat serum, 10 minutes at room temperature. Primary antibody: HA750126, 1/1,000, 1 hour at room temperature. Secondary antibody: HA1119, 20 minutes at room temperature. |

|
Fig8:
Application: Immunohistochemistry (IHC-P) Species: Rat Tissue: Small intestine Sample: Paraffin-embedded section Antigen retrieval: Heat-mediated, Tris-EDTA buffer (pH 9.0), 20 minutes at 95℃. Wash buffer: 1× TBST Endogenous peroxidase blocking: 3% H₂O₂, 10 minutes at room temperature. Blocking: 1% BSA + 10% normal goat serum, 10 minutes at room temperature. Primary antibody: HA750126, 1/1,000, 1 hour at room temperature. Secondary antibody: HA1119, 20 minutes at room temperature. |
|
Fig9:
Application: Flow Cytometry (Intra) Species: Human Sample: Hep G2 (Human liver cancer cells) Fixation: 4% Paraformaldehyde, 15 minutes at room temperature. Permeabilization: 1x Permeabilization Buffer (eBioscience), 15 minutes at room temperature. Blocking: 1% BSA + 10% normal goat serum, 15 minutes at room temperature. Antibody dilution buffer: 1x PBS. Primary antibody: HA750126 (1/1,000) (Red) compared with Rabbit IgG Isotype Control (HA722127, Green), 15 minutes at room temperature. Secondary antibody: Goat Anti-Rabbit IgG (iFluor™ 488, HA1121), 15 minutes at room temperature. |
Note: All products are “FOR RESEARCH USE ONLY AND ARE NOT INTENDED FOR DIAGNOSTIC OR THERAPEUTIC USE”.